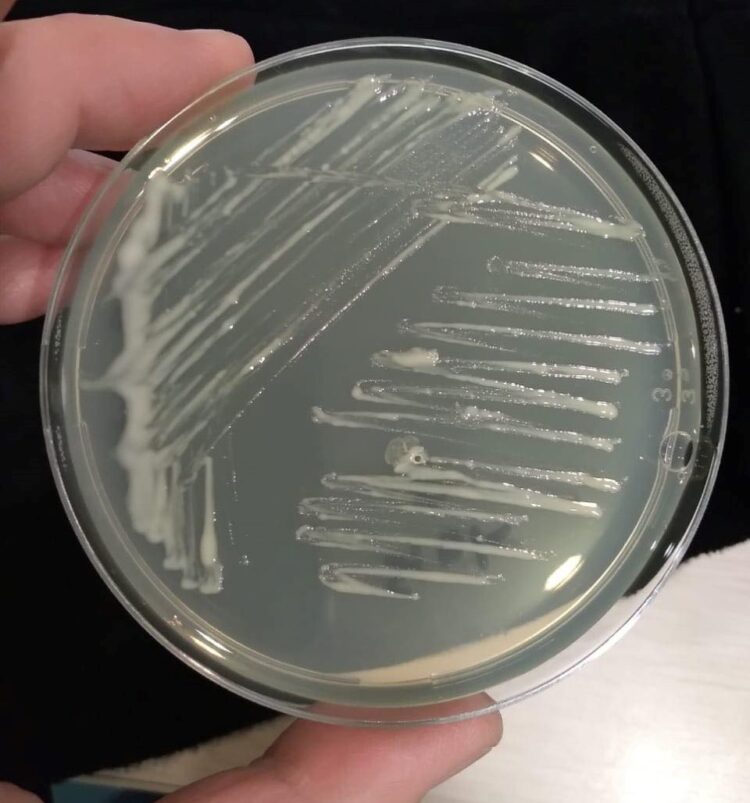
Investigadores describen nueva especie bacteriana

La nueva especie descrita como PVT-9aT fue aislada de una lesión en la piel de un ejemplar de salmón Atlántico durante un brote de tenacibaculosis causado por T. dicentrarchi ocurrido en 2016 en un centro de cultivo.
La tenacibaculosis fue reconocida por el Servicio Nacional de Pesca y Acuicultura en junio del 2018 y desde entonces se reporta en la clasificación de mortalidades, convirtiéndose las bacterias del género Tenacibaculum en la segunda causa de muerte del salmón del Atlántico cultivado en Chile.
La publicación de INCAR indica que “desde 2016, nuestro grupo de investigación ha intensificado los muestreos sanitarios de peces con tenacibaculosis en la Patagonia chilena, así como el aislamiento de bacterias consistentes con las características del género Tenacibaculum.
De hecho, hemos detectado la existencia de coinfecciones por distintas especies del mismo género, como ocurrió con T. dicentrarchi y la nueva especie T. bernardetii, así como en otras bacterias en que actualmente estamos trabajando para determinar su posición taxonómica».

Nuevo aporte
En esta nueva publicación, informamos el aislamiento, caracterización e identificación de la cepa tipo PVT-9aT y la denominamos Tenacibaculum bernardetii en honor al aporte realizado por el Profesor Jean Francois Bernardet (Francia), microbiólogo que dedicó su vida al estudio de la familia Flavobacteriaceae, a la que pertenece el género Tenacibaculum”, informaron los investigadores en la publicación científica donde dieron a conocer el nuevo descubrimiento.
El estudio da cuenta del avance «con esta nueva descripción, los Tenacibaculum descritos se incrementan a 34 especies y futuros estudios debieran ser realizados para determinar si la nueva especie tiene el potencial de provocar mortalidades en salmón del Atlántico y confirmar los postulados de Koch.
Sin embargo, estas bacterias también podrían ser parte de la microbiota del ambiente acuático marino o podrían actuar sinérgicamente con T. dicentrarchi u otras bacterias para favorecer el proceso infeccioso. Precisamente, el proyecto FONDECYT 1230068 nos permitirá profundizar en las coinfecciones causadas por distintos miembros de Tenacibaculum», explicó el Investigador de INCAR y Académico de la Universidad Andrés Bello, Dr. Ruben Avendaño», añade el documento.
Hasta la fecha, en salmónidos cultivados en Chile el equipo liderado por el Dr. Avendaño-Herrera ha descrito las especies T. dicentrarchi, T. maritimum, T. finnmarkense, T. ovolyticum y descrito las nuevas especies T. piscium (descubierta el año 2020) y ahora T. bernardetii.
Lea el estudio completo de la descripción de esta nueva bacteria “Tenacibaculum bernardetii sp. nov., isolated from Atlantic salmon (Salmo salar L.) cultured in Chile”.